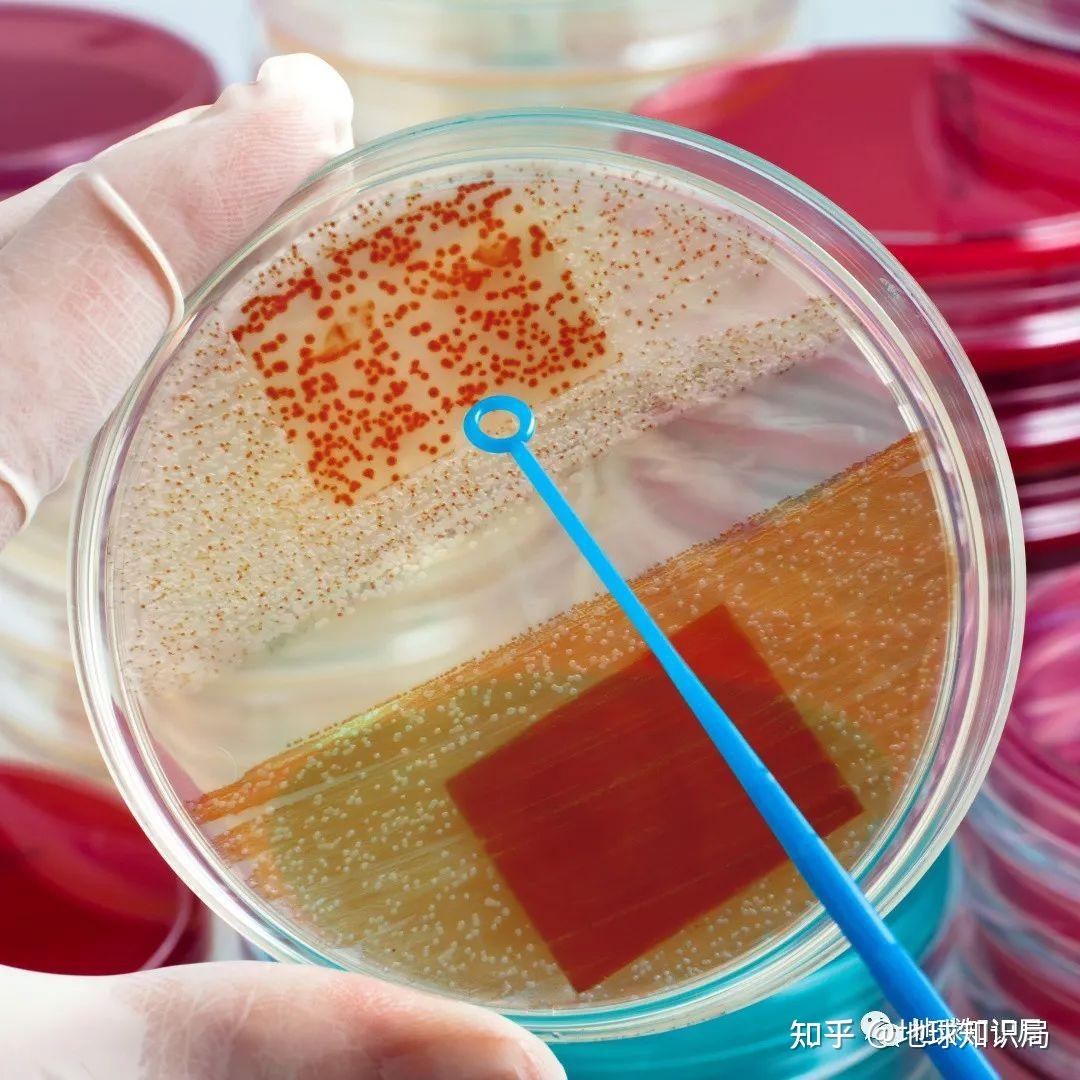

|
|
 发表于 2023-3-17 08:19:00
|
发表于 2023-3-17 08:19:00
|
查看: 293 |
回复: 0
(⊙_⊙)
每天一篇全球人文与地理
微信公众号:地球知识局
NO.2425-什么是甲流
作者:子昱
制图:澄澈 / 校稿:朝乾 / 编辑:清水鱼
前一周,我有一个同事(确切说是局长)感染了甲型流感,开始还以为是感冒发烧,但从后续的症状来看,无疑是甲流,拖拖拉拉一周才好。
当时,他还在朋友圈问了一下,有34个人说自己也甲了,虽然他的通讯录有5000人之多,但考虑到看到这一条的估计只是很小一部分,这个比例其实也不低。
面对本轮流感疫情,很多人不禁疑惑:今年的甲流为何如此汹涌?这些病例是不是新冠变异毒株带来的?
甲型流感对许多人来说其实并不陌生
一些地方的宣传标语还昭示着它存在过的证据
(图:Flickr / 壹图网)▼


事实上,流感病毒在世界上存在已久,人类与之斗争近百年,依然不能完全控制它。至今全球每年依然有超过十亿人感染。
来势汹汹的甲型流感,才一个月就肆虐开来
(图:WHO)▼

黑暗幽灵
由于流感并没有任何独有的症状,因而在古代人们通常都将流感归于其他各种疾病,古代文献中记录的疾病也没有专门的流感章节,我们目前只能通过当年记载的各种症状推断流感在古代的流行情况。
例如汉末三国时期的“建安大疫”席卷整个中原地区,加上连年战争,夺走数千万人口的生命。史书中记载患者感染瘟疫后起病迅速,通常表现为高热,并很快丧失劳动能力,且传染率和死亡率都极高。
赤壁之战时期,魏军大本营就流行着瘟疫
加上战败,死伤惨重,曹操才引归
(图:wiki)▼

医圣张仲景在《伤寒论》中记载:“卒然遭邪风之气,婴非常之疾,患及祸至,而方震栗...其死亡者,三分有二,伤寒十居其七。”
但张仲景说的“伤寒”指的是中医理论中寒邪侵犯人体导致的疾病,现在看来是多种疾病的统称,至于是否包括至今仍然让人头疼不已的流感,仍有待商榷。
今天常说的伤寒是由伤寒沙门氏菌引起的传染病
有些患者会起玫瑰疹(图:wiki)▼

1485年8月,许多英国人突然出现伴有高烧、咽喉灼热、头痛等症状的怪病,这些患者通常大汗淋漓,因而该病也被称为“汗热病”。这种疾病通常突然出现,过段时间又会神秘消失,周而复始。此后百年间汗热病5次袭击英国,造成数万人死亡。
汗热病让英国人印象深刻,因其受害者多为社会名流
另一方面,疾病的突发性和快速致命性也让人苦恼
(受汗热病侵袭的都铎王室,来源:《狼厅》剧照)▼

但无论是“伤寒”还是“汗热病”,单从记录来看,都不能完全与彼时可能出现的其它诸如鼠疫等烈性传染病区别开。直到1580年,流感再次袭来,西班牙、意大利等地死亡数十万人。
英国经济学家威廉·贝弗里奇爵士(William Beveridge)称,“在短短六周时间里,这场流感几乎传染并覆盖至了所有欧洲国家,其中没有被感染上流感的人数仅占人口总数的二十分之一左右。”
学者们认为,这是有明确记录的首次真正意义上的流感流行。
一些西班牙和意大利的城市在这场大流行中几乎灭城 ▼


在这之后,世界范围内流感呈现周期性爆发,平均每隔二三十年就会有一次大范围流行。至今全球共有31次流感大流行的记录,其中最恐怖的莫过于1918年的大流感,造成约5000万人死亡。
但即便人类与之缠斗数百年,至1918大流感时,都不太清楚流感究竟是什么原因造成的。
1918大流感的威力之猛难以估量
造成的损失超过同时期的第一次世界大战
(图:壹图网)▼

揭开面纱
1357年,西方首次出现了“流感”这个名称用以描述这种来去如风的传染性疾病:influenza。这个词来源于意大利语,据估计原因可能是因为人们发现疾病与寒冷的天气(influenze di freddo)有关。
但长期以来,人们只能根据症状给疾病命名,以至于今人难以根据文献记载追溯疾病的病原体。
直到1899年,人类才第一次发现并命名“病毒”这一概念
此前还一直认为流感的罪魁祸首是细菌
(流感病毒电镜观,图:Flickr)▼

19世纪末,德国细菌学家理查德·费佛(Richard Pfeiffe)从一名死于流感的患者鼻腔黏膜中分离出一种细菌,命名为“流感芽孢杆菌”。
彼时细菌学方兴未艾,加之费佛是细菌学泰斗罗伯特·科赫的得意门生,几乎所有人都对他提出的理论深信不疑:这种细菌是导致流感的罪魁祸首。
由于费佛在霍乱和伤寒治疗领域的贡献
大家对于他的“‘细菌’流感论”很买账
(图:shutterstock)▼

直到30年后,1918大流感爆发期间,人们依然是基于针对细菌的治疗方法来治疗流感,不过效果并不理想。此时越来越多的人开始怀疑在流感杆菌以外,是否还有其它致命的微生物存在。
细菌和病毒的感染机制完全不同
接种细菌疫苗,自然对于病毒性疾病收效甚微
(图:壹图网)▼

1931-1932年间,理查德·肖普(Richard Shope)等几位美国医学家相继提取出流感患者的鼻腔黏液,并使用细菌过滤器予以过滤。最终在针对猪的试验中发现,单独的流感杆菌并不会造成流感,反而是细菌过滤器过滤后的液体可以引发明显的流感症状。
肖普认为,造成流感的是一种病毒,且该病毒可以在人与其它动物之间交叉传播。
甲流病毒最开始就是肖普和他的导师在猪鼻子里发现的
再加上人鼻腔粘液中的实验,他推测病毒能交叉传播
(图:Flickr)▼

1933年,人们成功分离出第一种人流感病毒,此后陆续在1940、1949年分离出另外两种流感病毒。目前这几种流感病毒分别被命名为甲(A)型流感病毒、乙(B)型流感病毒、丙(C)型流感病毒。
由于甲型流感病毒具有传播速度快、途径广等特征,且容易发生变异,迄今为止造成多次世界范围的大流行。目前在我国造成许多人感染的也正是甲型流感病毒。
甲流病毒是正黏液科病毒中的一员。依据病毒表面的神经氨酸酶(NA)和血凝素(HA)分类。甲流病毒包括多种亚型,著名的有造成1918大流感的H1N1,死亡率高达50%的H5N1,2013年新发现的H7N9,以及H3N2、H2N2等。
▼

最重要的是,不同亚型的甲流病毒之间可以发生抗原漂变,也就是病毒变异。在下图中,H3型甲流病毒与H2N2型甲流病毒间发生抗原漂变,可以出现新的亚型H3N2。
病毒的抗原漂变的过程,有点类似于“杂交” ▼

虽然抗原漂变发生概率低,但目前为止,全世界甲流病毒中共发现16种HA以及9种NA,且每年感染甲流的人数众多,不能排除未来出现新的病毒亚型。
防治流感
甲流病毒通常通过空气传播,感染人体后有18-72小时的潜伏期,而后感染者可能出现高热、寒颤、头痛、全身无力、肌肉和关节疼痛、眼睛发红等症状,以及鼻炎、喉咙痛、干咳等呼吸道症状。
成人发热3天左右退烧,病毒在1周后可被人体消灭,但咳嗽等症状可能持续数周。
发烧发热算是常见,严重的还会上呼吸机,值得警惕
(图:Flickr)▼

虽然目前认为流感是一种自限性疾病,但其继发的细菌性肺炎对于免疫力低下的人群极其凶险,以往流感致死的患者中,有许多都是死于继发性肺炎及其并发症等。
因此,更好地认识流感,做到早诊早治对于个人的预后也有极大帮助。同时,流感病毒并不单单以人类为宿主,研究者也需要更好地了解允许甲型流感病毒在物种间传播和适应新宿主的决定因素,有助于早期识别出现的流感病毒,并进行风险评估。
流感病毒拥有强大的跨物种传播能力
(图:frontiersin)▼

流感病毒在自然界的宿主相当多,并且部分水禽感染流感病毒后并不表现出症状,但人类饲养的家禽、宠物、牲畜等在外接触病毒后也会染疫,最终可能传给人类。
这也是世界各国面临禽流感时
都要大范围扑杀禽鸟的原因
(图:壹图网)▼

由于流感病毒分布范围广,与人类关系密切,每年流感流行季期间,预防流感也是重中之重,毕竟没有人愿意经受一次流感的考验。
目前预防流感的措施主要包括戴口罩、勤洗手、接种疫苗等。其中,疫苗不仅可以预防当季的流感,还能减少重症的发生率。
流感的常见预防措施
(图:壹图网)▼

但由于每年的流感毒株都可能有所不同,疫苗也应针对性选择;且鉴于北半球流感高发季从当年的10月一直持续到第二年的5月,因而世卫组织也建议若需要接种疫苗尽量在初秋时节接种。
如若感染流感,也应及时、尽早诊治。目前治疗流感的药物以抗病毒药物为主,包括奥司他韦、扎那米韦、帕拉米韦、玛巴洛沙韦等,对于适用人群有着不俗的效果。对于老年患者或免疫力低下等人群,还要注意观察,避免肺炎等并发症的出现。
以玛巴洛沙韦为例,在细胞内通过代谢产物巴洛沙韦
作为酶抑制剂,抑制流感病毒核酸的复制过程 ▼

除此以外,控制家禽、家畜以及宠物的活动也可以在一定程度上从源头阻止流感的传播。
放养的家禽在外很容易被携带流感病毒的野鸟感染
(图:shutterstock)▼

不管怎么说,流感是离我们最近的传染病之一,我们也不应轻视流感,每年各国都要花费大力气用于宣传、防治流感,流感的周期性爆发也是世界公共卫生领域的一大挑战。
尽管目前的抗病毒药物已经非常成熟,但我们依然不能掉以轻心,每年全球因为流感而死亡的人数高达50万。我们也不应把希望全部寄托在疫苗身上,目前的季节性人流感疫苗需要每年接种;且可能碰到流感毒株和疫苗不匹配的情况。
力不从心,疫苗难以对抗快速迭代变化的流感病毒
(图:shutterstock)▼

如今,距离1918大流感已经过去了一百多年,我们依然没能找到彻底消灭流感的办法。我们对于流感的认识就如同对于这个世界的认识一样,还有很多未解之谜。
参考资料:
[1] Gaitonde DY, Moore FC, Morgan MK. Influenza: Diagnosis and Treatment. Am Fam Physician. 2019. 100(12): 751-758.
[2] Ghebrehewet S, MacPherson P, Ho A. Influenza. BMJ. 2016. 355: i6258.
[3] Javanian M, Barary M, Ghebrehewet S, Koppolu V, Vasigala V, Ebrahimpour S. A brief review of influenza virus infection. J Med Virol. 2021. 93(8): 4638-4646.
[4] Krammer F, Smith G, Fouchier R, et al. Influenza. Nat Rev Dis Primers. 2018. 4(1): 3.
[5] Sullivan SJ, Jacobson RM, Dowdle WR, Poland GA. 2009 H1N1 influenza. Mayo Clin Proc. 2010. 85(1): 64-76.
[6] [美] 杰瑞米·布朗. 致命流感. 社会科学文献出版社. 2020.
*本文内容为作者提供,不代表地球知识局立场
封面:壹图网
据说地球人民都关注分享我局了(⊙v⊙)
地球知识局微信公众号:地球知识局

END |
|